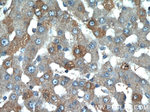
CCL27 Antibody in Immunohistochemistry (Paraffin) (IHC (P))

Search
Proteintech
CCL27 Polyclonal Antibody
{{$productOrderCtrl.translations['antibody.pdp.commerceCard.promotion.promotions']}}
{{$productOrderCtrl.translations['antibody.pdp.commerceCard.promotion.viewpromo']}}
{{$productOrderCtrl.translations['antibody.pdp.commerceCard.promotion.promocode']}}: {{promo.promoCode}} {{promo.promoTitle}} {{promo.promoDescription}}. {{$productOrderCtrl.translations['antibody.pdp.commerceCard.promotion.learnmore']}}
产品信息
22301-1-AP
种属反应
宿主/亚型
分类
类型
抗原
偶联物
形式
浓度
规格
纯化类型
保存液
内含物
保存条件
运输条件
靶标信息
CCL27 gene is one of several CC cytokine genes clustered on the p-arm of chromosome 9. Cytokines are a family of secreted proteins involved in immunoregulatory and inflammatory processes. The CC cytokines are proteins characterized by two adjacent cysteines. The protein encoded by this gene is chemotactic for skin-associated memory T lymphocytes. This cytokine may also play a role in mediating homing of lymphocytes to cutaneous sites. It specifically binds to chemokine receptor 10 (CCR10). Studies of a similar murine protein indicate that these protein-receptor interactions have a pivotal role in T cell-mediated skin inflammation.
仅用于科研。不用于诊断过程。未经明确授权不得转售。
篇参考文献 (0)
生物信息学
蛋白别名: C-C motif chemokine 27; CC chemokine; CC chemokine ILC; chemokine (C-C motif) ligand 27; CTACK; cutaneous T-cell attracting chemokine; Cutaneous T-cell-attracting chemokine; ESkine; IL-11 R-alpha-locus chemokine; IL-11 Ralpha-locus chemokine; Skinkine; small inducible cytokine subfamily A (Cys-Cys), member 27; Small-inducible cytokine A27
基因别名: ALP; CCL27; CTACK; CTAK; ESKINE; ILC; PESKY; SCYA27
UniProt ID: (Human) Q9Y4X3
Entrez Gene ID: (Human) 10850